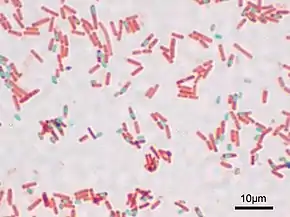

Endospore
L’endospore ou spore est une structure qui se forme au sein du cytoplasme de certaines espèces de bactéries lorsque les conditions environnementales sont défavorables (stress nutritif, dessiccation, chaleur…). L’endospore permet à la bactérie de survivre à ces conditions défavorables dans un état de vie ralentie (état de dormance). L’endospore représente donc une forme de résistance mais aussi une forme de dissémination.
Les bactéries des genres Clostridium, Bacillus, Sporosarcina sont des exemples de bactéries pouvant sporuler. Dans certaines classifications taxonomiques les bactéries pouvant sporuler sont regroupées dans un seul sous-embranchement : les endobactéries (ou Endobacteria).
Les endospores sont très résistantes : elles résistent à la dessiccation, à la chaleur (thermorésistance), aux radiations, aux antibiotiques, aux antiseptiques… De plus leur longévité peut être importante (elles pourraient atteindre plusieurs milliers d’années pour certaines espèces de Bacillus).
Structure de la spore

La spore contient notamment des acides nucléiques (ADN et ARN) et des protéines. Le cytoplasme est déshydraté. La spore est entourée d’une paroi sporale, d’un cortex (composé d’un peptidoglycane spécifique et de dipicolinate de calcium), d’une double tunique constituée de protéines fibreuses. La couche la plus externe est l’exosporium.
La sporulation est le phénomène de formation de la spore.
La germination est le phénomène inverse de retour à la cellule active, lorsque les conditions redeviennent favorables.
Propriétés de la spore
Les endospores constituent des formes de vie très résistantes. Elles peuvent résister à des températures très élevées, à la pression, aux rayons UV ou X, aux désinfectants, aux antiseptiques et aux antibiotiques.
La thermorésistance des spores varie d’une espèce à l’autre. Elles survivent après chauffage à 70-80 °C mais sont en général toutes détruites à l’autoclave à 120 °C pendant 20 minutes, ce qui fait éclater leurs enveloppes de protection.
La longévité des spores peut être très importante, peut-être jusqu’à plusieurs dizaines ou centaines de milliers d’années. La germination et la croissance de spores retrouvées dans des momies égyptiennes embaumées depuis plusieurs millénaires ont été observées.
Plusieurs facteurs peuvent avoir un rôle dans la résistance des spores : l’état déshydraté des constituants cytoplasmiques ; la présence du complexe acide dipicolinique-calcium qui stabiliserait les acides nucléiques de la spore. Les tuniques (interne et externe) rendent la spore imperméable et sont responsables de la résistance aux agents chimiques.
Des spores de bactéries ont été transportées sur Mars lors des différentes missions d’exploration de la planète. Cependant, ces spores sont à l’état de dormance et ne pourront vraisemblablement pas germer car non adaptées à l’environnement martien. Les techniques de stérilisation des sondes et satellites devront toutefois être améliorées pour ne pas interférer avec les recherches de vie sur d’autres planètes.
Les étapes de la sporogenèse
La sporogenèse (formation de l’endospore) débute par une division cellulaire asymétrique. Après la duplication du chromosome, la membrane plasmique s’invagine et forme un septum transversal qui divise la cellule en deux parties inégales. La plus petite correspond à la préspore. Ensuite la préspore s’enkyste, il y a formation du cortex et de la tunique sporale (phase de maturation). La partie la plus grande de la cellule (sporange) est lysée ce qui permet la libération de la spore.
La germination
La germination ne peut se produire qu’en milieu hydraté. Bien souvent, une activation par la chaleur est nécessaire ainsi que la présence de certains nutriments (sucres, acides aminés). La spore se réhydrate, les enveloppes se rompent, l’activité métabolique augmente ; la germination aboutit à la naissance d’une cellule végétative qui subira plusieurs mitoses pour former une bactérie dans le cas d'une endospore[1].
Mise en évidence des spores ou du pouvoir sporogène
Cette mise en évidence peut se faire de deux manières :
- une méthode rapide : la coloration au vert de malachite ;
- une méthode lente : on prélève un échantillon de culture pure (environ 1 mL) et le fait chauffer pendant 10 minutes à 80 °C. On dépose ensuite un peu de cette préparation sur un milieu nutritif que l’on place à incuber dans les conditions optimales de culture de la souche étudiée. Si on observe un développement de la culture, la souche est sporogène.
Implication en santé
L’existence de bactéries sporulées a des conséquences en santé publique. Les endospores résistant aux antiseptiques, la stérilisation du matériel médical doit être rigoureuse.
Certaines bactéries sporulées sont pathogènes : Bacillus cereus et Clostridium botulinum peuvent provoquer des toxi-infections alimentaires. D’autres espèces peuvent entraîner une altération des denrées alimentaires (Bacillus stearothermophilus, etc.)
Quand la stérilisation en autoclave n’est pas possible, une autre façon de les tuer est de les exposer pendant une courte durée aux rayonnements ionisants à haute énergie (gamma ou préférablement bêta) qui déstructurent le génome interne des spores (voir Irradiation des aliments). Cette technique est couramment utilisée dans l’industrie agro-alimentaire (par exposition au rayonnement émis par des capsules de cobalt radioactif de synthèse 60Co émetteur de particules β−, des électrons à haute vitesse) pour la stérilisation des fruits et légumes frais contre nombre de bactéries pathogènes ubiquitaires, qu’elles soient à l’état vivant, végétatif ou sporulé. Les rayonnements utilisés ne sont toutefois pas assez énergiques pour casser les noyaux atomiques et ne produit pas de nouveaux noyaux radioactifs. Cette méthode de stérilisation comporte toutefois des risques de manipulation car elle peut aussi bien détruire un génome animal, elle est donc totalement automatisée et pratiquée uniquement en environnement industriel ou sévèrement contrôlé.
Notes et références
- (en) Paula Hernández Calvo, Noelia Calvo Sánchez et Juan Luis Muñoz Bellido, « General Characteristics of Bacteria », dans Encyclopedia of Infection and Immunity, Elsevier, (ISBN 978-0-323-90303-5, DOI 10.1016/b978-0-12-818731-9.00219-6, lire en ligne), p. 481–491